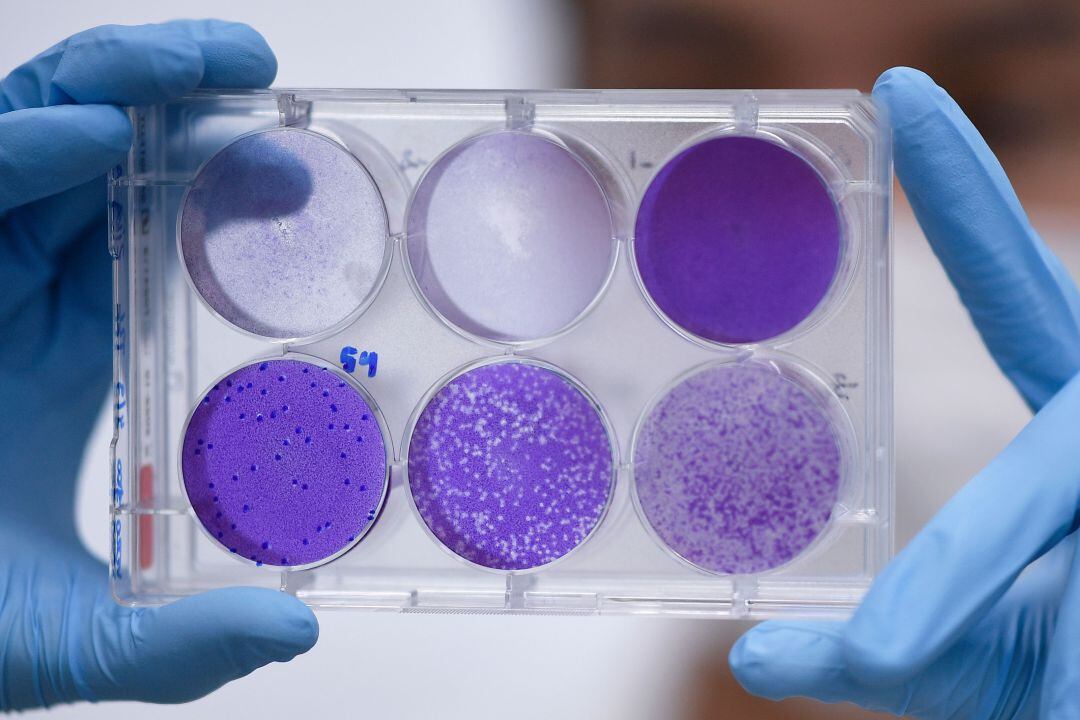
¿Podría una vacunación no específica ser una estrategia efectiva con el Covid-19?

¿Podría una vacunación no específica ser una estrategia efectiva contra el COVID-19?
El coronavirus deja ya en España 56.188 contagios y 4.145 muertos

¿Podría una vacunación no específica ser una estrategia efectiva con el Covid-19? / Getty Images
Madrid
Miguel Barajas (*1), Alfredo Resano (*2) y Eduardo Huarte.
1. Departamento de Ciencias de la Salud, Facultad de Ciencias de la Salud, Universidad Pública de Navarra, Pamplona. España.
2. Servicio de Alergología. Clínica San Miguel. Pamplona. España.
*Autor para correspondencia: miguel.barajas@unavarra.es
Introducción
La aparición del síndrome respiratorio agudo severo inducido por coronavirus 2 (SARS‐CoV‐2, también llamado enfermedad 2019‐nCoV) (COVID‐19), que se informó por primera vez en China en diciembre de 2019, ha causado un brote global importante y actualmente es el problema más grave de salud pública al que se ha enfrentado la humanidad en los últimos tiempos. Los datos de la Organización Mundial de la Salud (OMS) a fines de marzo de 2020 han demostrado que se hay más de 416.000 casos de personas infectadas por SARS‐CoV‐2 en 183 países, donde China, EEUU, Italia y España han acumulado el mayor número de casos. En España se han confirmado 56.188 casos y el número de fallecidos asciende a 4.145.
La búsqueda de una vacuna eficaz contra el SARS‐CoV‐2 se ha convertido en una de las prioridades que abordan los principales grupos de investigación en todo el mundo. Sin embargo, aunque se están realizando múltiples esfuerzos en el desarrollo de dicha vacuna, y a pesar del hecho de que las técnicas de generación de vacunas han mejorado considerablemente, no se espera una vacuna efectiva contra el SARS‐CoV‐2 hasta 2021. Por esta razón, el desarrollo de tratamientos alternativos disponibles para uso inmediato se ha convertido en una necesidad. En este sentido, planteamos la siguiente hipótesis: un entorno inflamatorio generado de manera anticipada y preventiva mediante el uso de una vacuna ya conocida podría potenciar la respuesta específica contra el SARS‐CoV‐2.
Estado del arte
Se ha demostrado que el uso de múltiples antígenos durante un protocolo de vacunación/inmunización aumenta las tasas de éxito de la vacunación (1). En el presente documento planteamos la hipótesis de que un entorno proinflamatorio (citocinas proinflamatorias, activación de las células del sistema inmunitario, etc.) generado por antígenos presentados por una vacuna puede tener un efecto sinérgico con otras vacunas o, por extensión, para el desarrollo de una respuesta inmune efectiva contra antígenos de SARS‐CoV‐2. Tal activación "no específica" del sistema inmunitario debería administrarse –idealmente– por vía nasal (2‐3), para así maximizar los efectos de la activación local del sistema inmune en las vías respiratorias, que es el tejido diana del SARS‐CoV‐2. Hay varios ejemplos disponibles de vacunas orales/nasales, incluida la gripe estacional (4‐5). Por otra parte, valorando las opciones que existen actualmente en el mercado español y, en caso de no poder disponer de la anteriormente mencionada vacuna antigripal por vía nasal, disponemos de una amplia experiencia en la inducción de respuestas inmunitarias inespecíficas gracias al uso de vacunas bacterianas. Desgraciadamente este tipo de vacunas dejaron de comercializarse en España en enero de 2018, pero tras haber contactado con un laboratorio nacional, nos han confirmado que su producción sigue activa para el mercado extranjero, por lo que existiría la posibilidad de disponer de ellas en caso de tener la aprobación por parte de la Agencia Española del Medicamento y Productos Sanitarios (AEMPS).
A pesar del fuerte sentimiento popular contra las vacunas en algunos países desarrollados, no hay evidencia que respalde los efectos secundarios asociados con las vacunas, y la comunidad científica los considera seguros incluso para las personas con mayor riesgo, como los ancianos con múltiples comorbilidades (6).
Curiosamente, los intentos de aumentar de forma no específica la respuesta inmune adaptativa han tenido éxito en varios entornos de cáncer (es decir, IL‐2, INF‐∞), y la vacuna Bacillus Calmette‐Guérin (BCG) se ha utilizado como inmunoterapia contra el cáncer de vejiga para más de 40 años (7). Sin embargo, hasta donde sabemos, todavía no existe un ensayo clínico para investigar si una respuesta inflamatoria no específica facilitará el desarrollo de una respuesta inmune contra el SARS‐CoV‐2.
Por otra parte, la presencia de títulos altos de IgG e IgM en el suero de las personas expuestas al SARS‐CoV‐2 y el hecho de que la mayoría de los pacientes pueden erradicar el virus indica claramente que un sistema inmunitario sano puede generar una respuesta inflamatoria contra los antígenos virales. Sin embargo, la velocidad y la fuerza de esta respuesta inmunitaria varían mucho entre pacientes o grupos de pacientes, lo que explica la diferencia en los resultados (desde un individuo asintomático hasta aquellos que requieren atención en la UCI o incluso fallecen). Proponemos el uso de una vacuna ya aprobada en aquellos sujetos que resultan ser positivos para el SARS‐CoV‐2. La aplicación de esta vacuna, de forma activa o preventiva, crearía un ambiente inflamatorio que facilitaría y aceleraría el desarrollo de una respuesta inmunitaria específica contra el SARS‐CoV‐2 y facilitaría la eliminación viral a través de:
i) Potenciar una respuesta inmunitaria efectiva en aquellos pacientes que han estado en contacto con el virus de manera temprana.
ii) Acelerar el aclaramiento viral en aquellas personas que, si bien sufren solo síntomas leves (o incluso pacientes asintomáticos) aún pueden infectar a otras personas, evitando así la propagación del virus en la población general.
iii) Proteger a los profesionales sanitarios que están en contacto con pacientes infectados con SARS‐CoV‐2.
Conclusiones
Como conclusión a la información expuesta podemos enumerar las ventajas e inconvenientes que presenta la estrategia presentada anteriormente:
Ventajas
- Las vacunas han sido ampliamente utilizadas por muchos segmentos de la población, sin ninguna evidencia del desarrollo de efectos secundarios asociados a ellas.
- Esta estrategia, junto con un aumento en las pruebas de pacientes infectados con SARS‐ CoV‐2, podría conducir a una disminución en el tiempo necesario para eliminar el virus y, por lo tanto, reducir el riesgo de propagación.
- Debido a que el SARS‐CoV‐2 afecta principalmente las vías respiratorias, planteamos la hipótesis de que una vacuna nasal será más efectiva para inducir una respuesta específica del SARS‐CoV‐2.
- La activación inmunitaria no específica que se describe también podría usarse potencialmente en otras patologías en las que el sistema inmunitario no puede generar una respuesta efectiva, tales como, el virus de la hepatitis C o el cáncer.
Inconvenientes
- Este tratamiento previsiblemente no sería eficaz en pacientes mayores que sufren el fenómeno denominado "tormenta de citoquinas", ya que podría conducir a un empeoramiento de los síntomas. En este subconjunto de pacientes, puede estar indicada una estrategia diferente, con el objetivo de regular negativamente el sistema inmunitario.
Preguntas por responder
- ¿Es el SARS‐CoV‐2 más agresivo en aquellos países donde los programas de vacunación no están extendidos en la población general? ¿Podría explicar las diferencias observadas entre países como Italia y Alemania (donde la vacunación contra el virus de la gripe se ha extendido hasta diciembre)?
Referencias
1. Keim‐Malpass J, Mitchell EM, Camacho F. (2015) HPV vaccination series completion and co‐vaccination: Pairing vaccines may matter for adolescents. Vaccine. 2015 Oct 26;33(43):5729‐5732. doi: 10.1016/j.vaccine.2015.09.077.
2. Ferreri AJ, Illerhaus G, Zucca E, Cavalli F; International Extranodal Lymphoma Study Group. (2010) Flows and flaws in primary central nervous system lymphoma. Nat Rev Clin Oncol. 2010 Aug;7(8):doi:10.1038/nrclinonc.2010.9‐c1.
3. Davis SS (2001) Nasal vaccines. Aadv Drug Deliv Rev. 2001 Sep 23;51(1‐3):21‐42.
4. Kusakabe T, Ozasa K, Kobari S, Momota M, Kishishita N, Kobiyama K, Kuroda E, Ishii KJ. (2016) Intranasal hydroxypropyl‐β‐cyclodextrin‐adjuvanted influenza vaccine protects against sub‐heterologous virus infection. Vaccine. 2016 Jun 8;34(27):3191‐3198. doi: 10.1016/j.vaccine.2016.04.001.
5. Kopsaftis Z, Wood‐Baker R, Poole P. (2018) Influenza vaccine for chronic obstructive pulmonary disease (COPD). Cochrane Database Syst Rev. 2018 Jun 26;6:CD002733. doi: 10.1002/14651858.CD002733.pub3.
6. Dos Santos G1, Tahrat H2, Bekkat‐Berkani R3. (2018) Immunogenicity, safety, and effectiveness of seasonal influenza vaccination in patients with diabetes mellitus: A systematic review. Hum Vaccin Immunother. 2018;14(8):1853‐1866. doi: 10.1080/21645515.2018.1446719.
7. Boehm BE1, Cornell JE1, Wang H1, Mukherjee N1, Oppenheimer JS1, Svatek RS2. (2017). Efficacy of bacillus Calmette‐Guérin Strains for Treatment of Nonmuscle Invasive Bladder Cancer: A Systematic Review and Network Meta‐Analysis. J Urol. 2017 Sep;198(3):503‐510. doi: 10.1016/j.juro.2017.01.086.
Content not defined
Miguel Barajas (*1), Alfredo Resano (*2) y Eduardo Huarte.
1. Departamento de Ciencias de la Salud, Facultad de Ciencias de la Salud, Universidad Pública de Navarra, Pamplona. España.
2. Servicio de Alergología. Clínica San Miguel. Pamplona. España.
*Autor para correspondencia: miguel.barajas@unavarra.es




